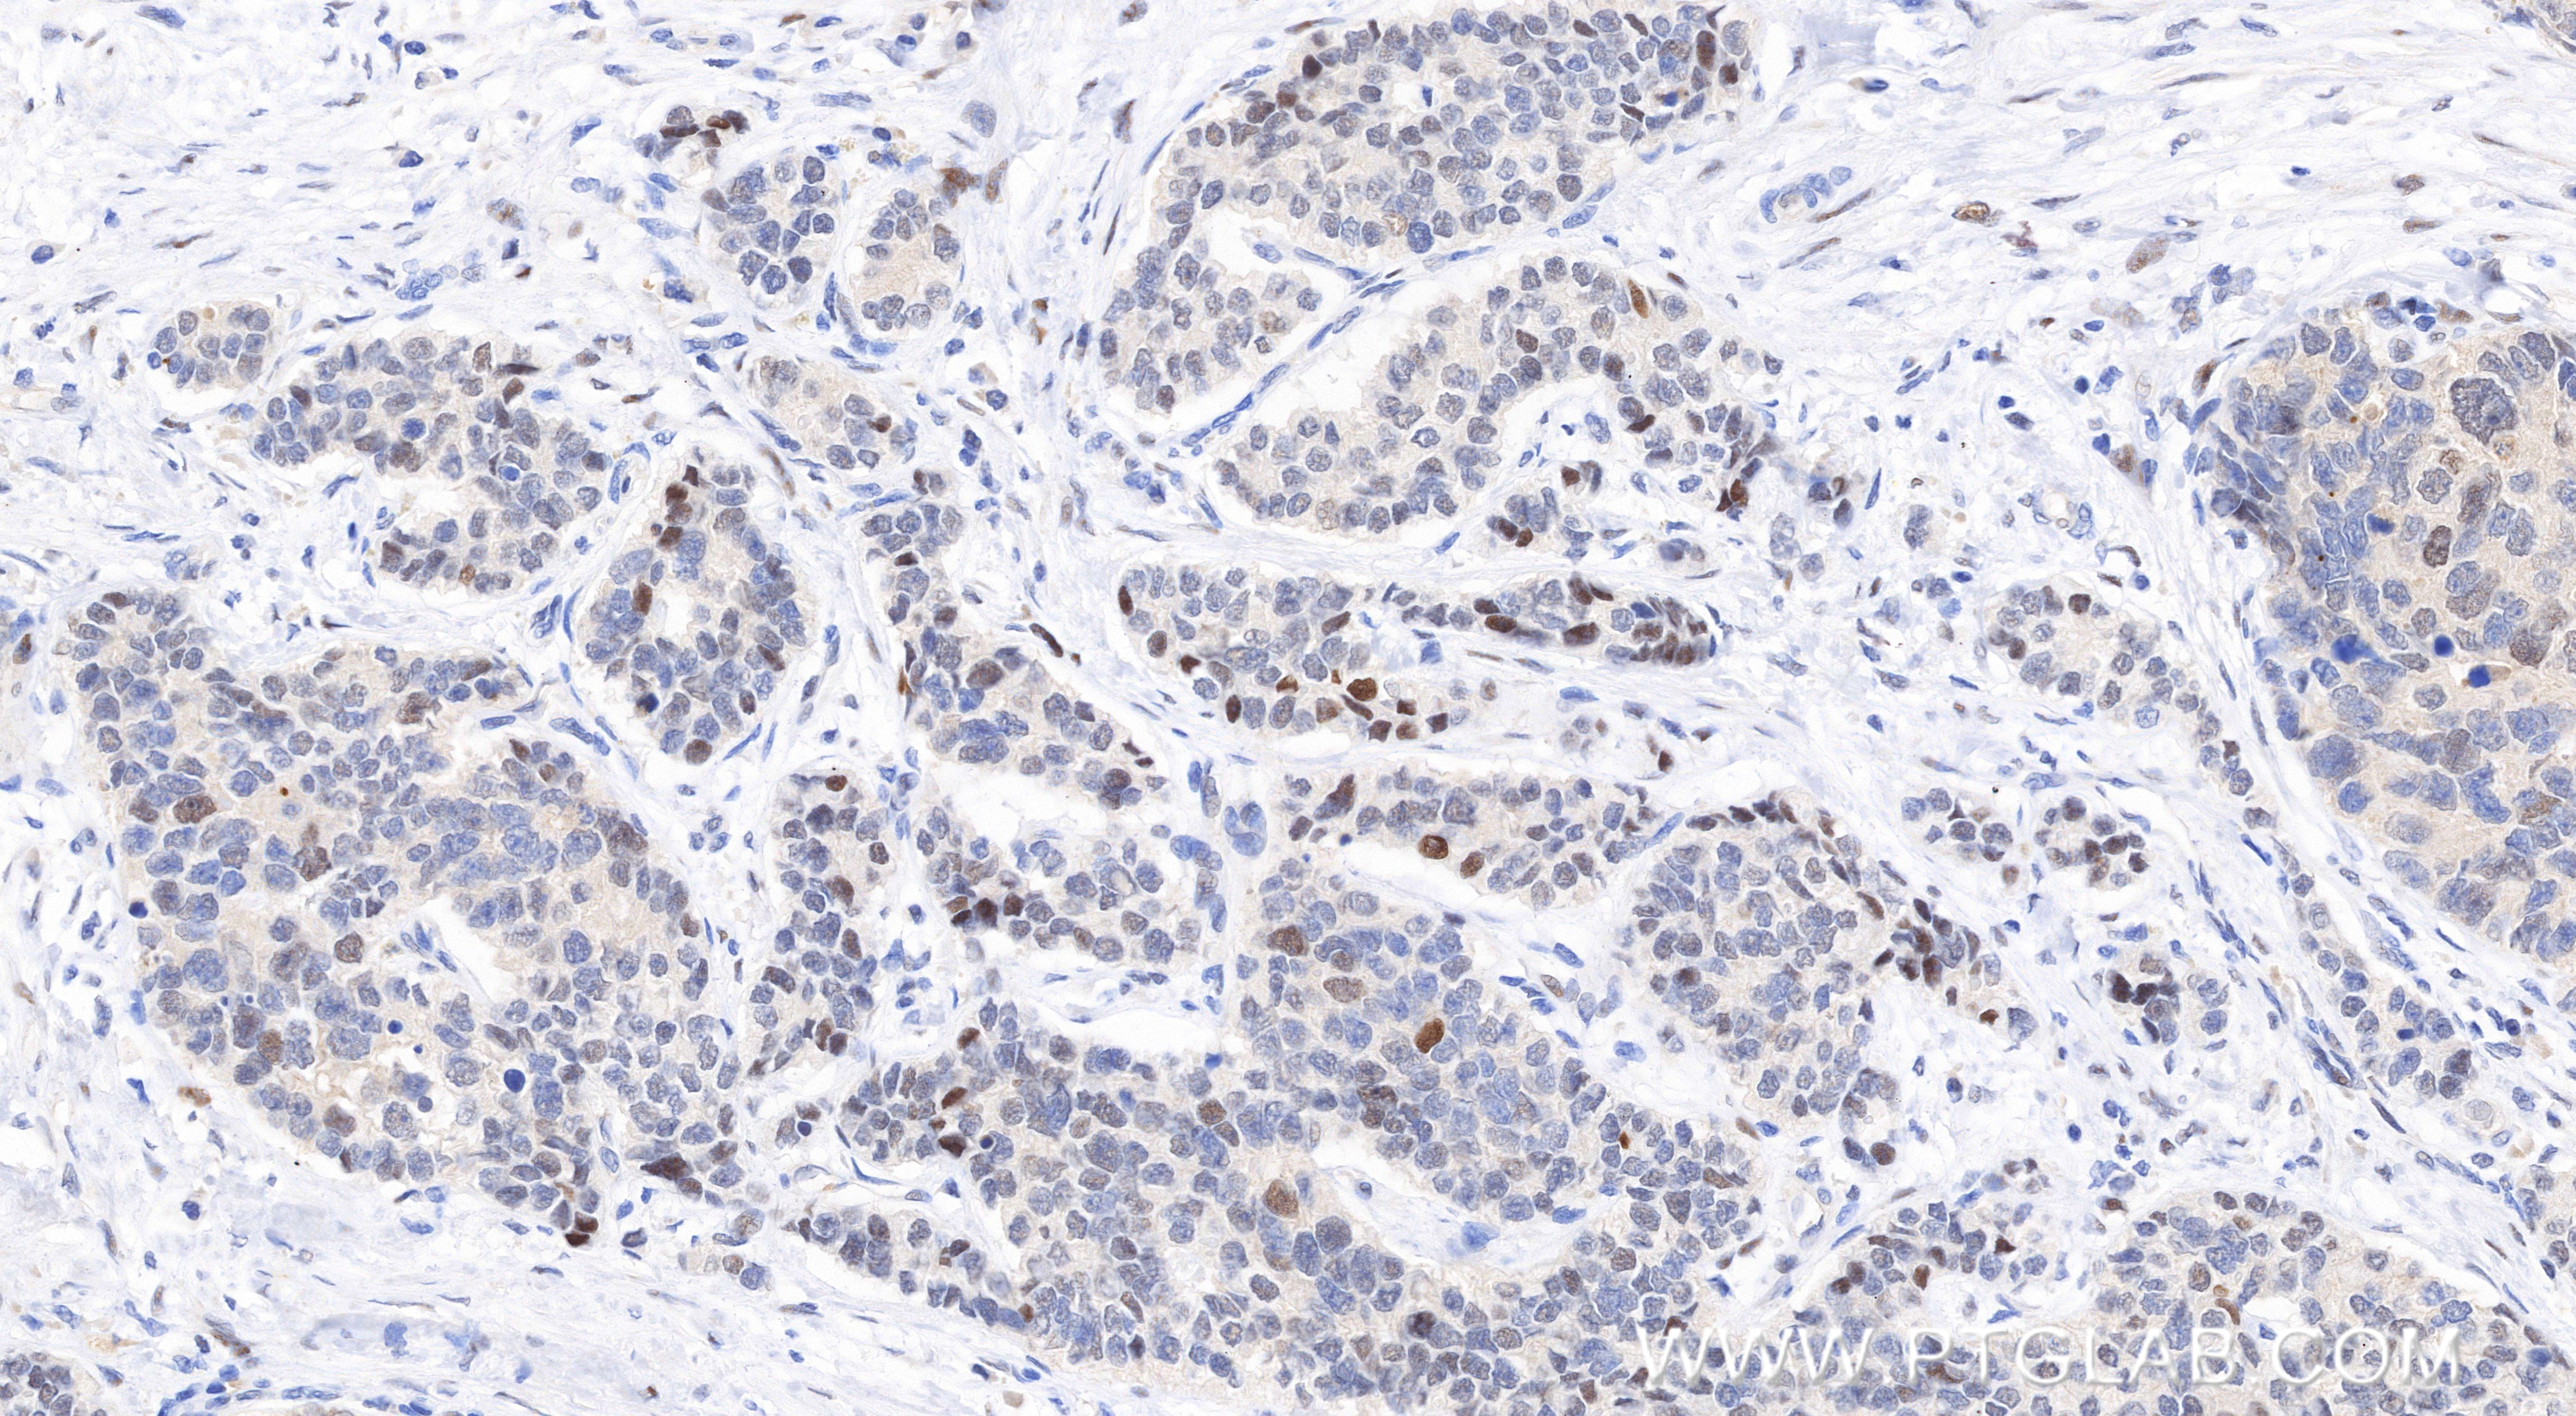
Immunohistochemical analysis of paraffin-embedded human stomach cancer tissue slide using 85675-5-RR (KIF23 antibody) at dilution of 1:1000 (under 20x lens). Heat mediated antigen retrieval with Tris-EDTA buffer (pH 9.0). This data was developed using the same antibody clone with 85675-5-PBS in a different storage buffer formulation. Immunohistochemistry (IHC) staining of human stomach cancer tissue using KIF23 Recombinant monoclonal antibody (85675-5-RR)

Product Information
85675-5-PBS targets KIF23 as part of a matched antibody pair:
MP02031-1: 85675-5-PBS capture and 85675-4-PBS detection (validated in Cytometric bead array)
MP02031-2: 85675-5-PBS capture and 85675-3-PBS detection (validated in Cytometric bead array)
Unconjugated rabbit recombinant monoclonal antibody in PBS only (BSA and azide free) storage buffer at a concentration of 1 mg/mL, ready for conjugation. Created using Proteintech’s proprietary in-house recombinant technology. Recombinant production enables unrivalled batch-to-batch consistency, easy scale-up, and future security of supply.
This conjugation ready format makes antibodies ideal for use in many applications including: ELISAs, multiplex assays requiring matched pairs, mass cytometry, and multiplex imaging applications.Antibody use should be optimized by the end user for each application and assay.
| Tested Reactivity | human |
| Host / Isotype | Rabbit / IgG |
| Class | Recombinant |
| Type | Antibody |
| Immunogen |
CatNo: Ag29346 Product name: Recombinant human KIF23 protein Source: e coli.-derived, PGEX-4T Tag: GST Domain: 486-683 aa of NM_138555 Sequence: LDINDEQTLPRLIEALEKRHNLRQMMIDEFNKQSNAFKALLQEFDNAVLSKENHMQGKLNEKEKMISGQKLEIERLEKKNKTLEYKIEILEKTTTIYEEDKRNLQQELETQNQKLQRQFSDKRRLEARLQGMVTETTMKWEKECERRVAAKQLEMQNKLWVKDEKLKQLKAIVTEPKTEKPERPSRERDREKVTQRSV Predict reactive species |
| Full Name | kinesin family member 23 |
| Calculated Molecular Weight | 110 kDa |
| GenBank Accession Number | NM_138555 |
| Gene Symbol | KIF23 |
| Gene ID (NCBI) | 9493 |
| Conjugate | Unconjugated |
| Form | Liquid |
| Purification Method | Protein A purification |
| UNIPROT ID | Q02241 |
| Storage Buffer | PBS only, pH 7.3. |
| Storage Conditions | Store at -80°C. |
Background Information
KIF23, also known as KNSL5 and MKLP1, is a member of the kinesin-like protein family. It plays a crucial role in cytokinesis, the final stage of cell division. It is involved in the formation of the central spindle, which is essential for the proper separation of the cytoplasm and the formation of the cleavage furrow. KIF23 is also involved in the organization and transport of intracellular vesicles and organelles. Mutations in KIF23 have been associated with congenital dyserythropoietic anemia type III(PMID: 23570799).